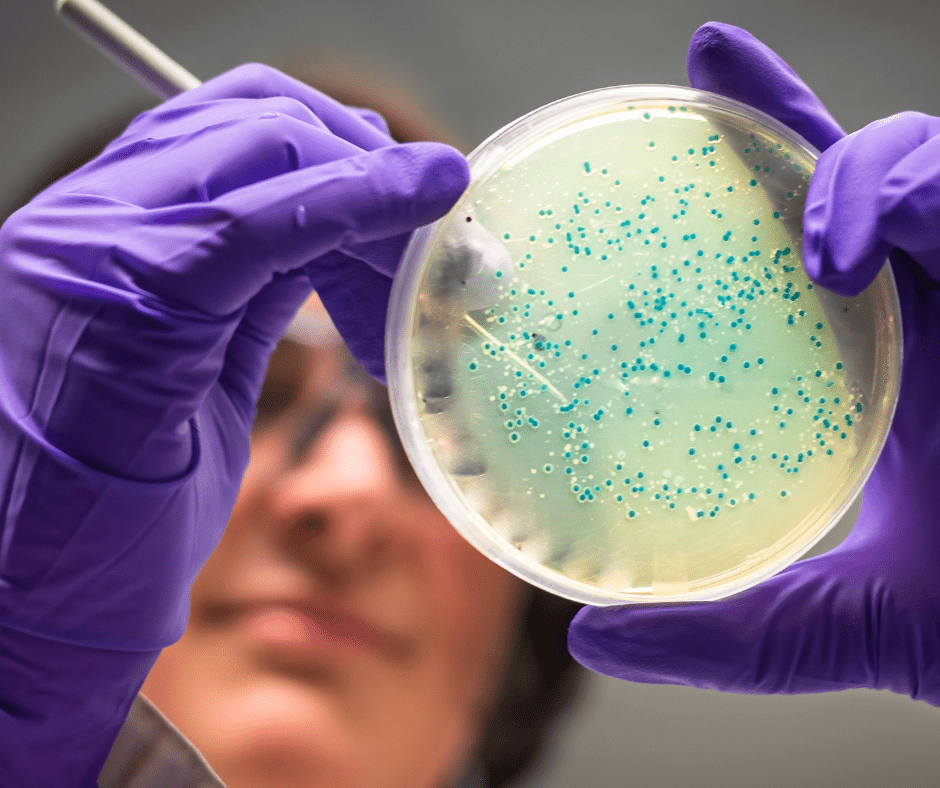

How does Alkaline Water affect the Microbiome?
Share
In 2023, a study was conducted by the University of Madrid, analyzing the effects of alkalized Alkanatur water on the microbiome of rats.
The study looked at the gut health of rats given different types of water to drink. They compared normal and obese rats drinking tap water, filtered water, or filtered water with added minerals (which was therefore made alkaline). They also gave some rats probiotics in their food.
The researchers checked the rats' weight gain, how their bodies burned calories, and signs of inflammation and stress. They also analyzed their stool to see what kind of bacteria were living in the gut, and examined the rats' intestines after they were done with the experiment.
The results showed that drinking alkaline water improved the gut bacteria and even the lining of the intestines. It also seemed to reduce inflammation and stress in the body, along with helping the rats utilize oxygen more efficiently.
Giving the rats probiotics along with the alkaline water seemed to make the positive effects even stronger. Overall, the study suggests that drinking alkaline water might be beneficial for gut health and overall well-being, with probiotics offering an additional boost.
This research builds on past studies that showed the benefits of alkaline water in reducing oxidative stress and inflammation in animals.
Previous findings:
- Drinking alkaline water lowered stress and inflammation in rats and mice (mentioned in another study).
Current 2023 study:
- Confirmed the previous findings in rats, especially normal weight rats.
- Alkaline water improved their inflammatory profile without affecting weight gain or antioxidant capacity significantly.
- It reduced levels of a harmful inflammatory molecule (IL-1) and increased levels of a beneficial one (IL-10).
- Researchers suspected the positive effects might come from the gut.
- They analyzed gut bacteria and found:
- Alkaline water increased "good" bacteria like Akkermansia.
- It decreased "bad" bacteria linked to gut imbalances (dysbiosis) like Enterobacteriaceae.
- These effects were more pronounced in normal weight rats.
- They gave probiotics (supplements with good bacteria) to obese rats.
- Probiotics had a different effect on their gut bacteria.
- They analyzed gut bacteria and found:
- The changes in gut bacteria were linked to:
- Improvements in the lining of the gut (both small and large intestines) in both normal and obese rats.
- A significant reduction in inflammatory cells in the gut.
- Lower levels of proteins damaged by oxidation (HNE) in the gut.
Overall Takeaways:
- Drinking alkaline water might improve gut health and reduce inflammation, leading to better overall health.
- This effect seems to be stronger in normal weight rats.
- The benefits might be related to changes in gut bacteria.
Important to note:
- This is a study in rats, and more research is needed to confirm if the same applies to humans.
Alkanatur Alkaline Water Filter Pitcher with Magnesium & Antioxidants – Alkanatur North America
Gut Feeling: How the Microbiome affects Mind & Mood – Alkanatur North America








